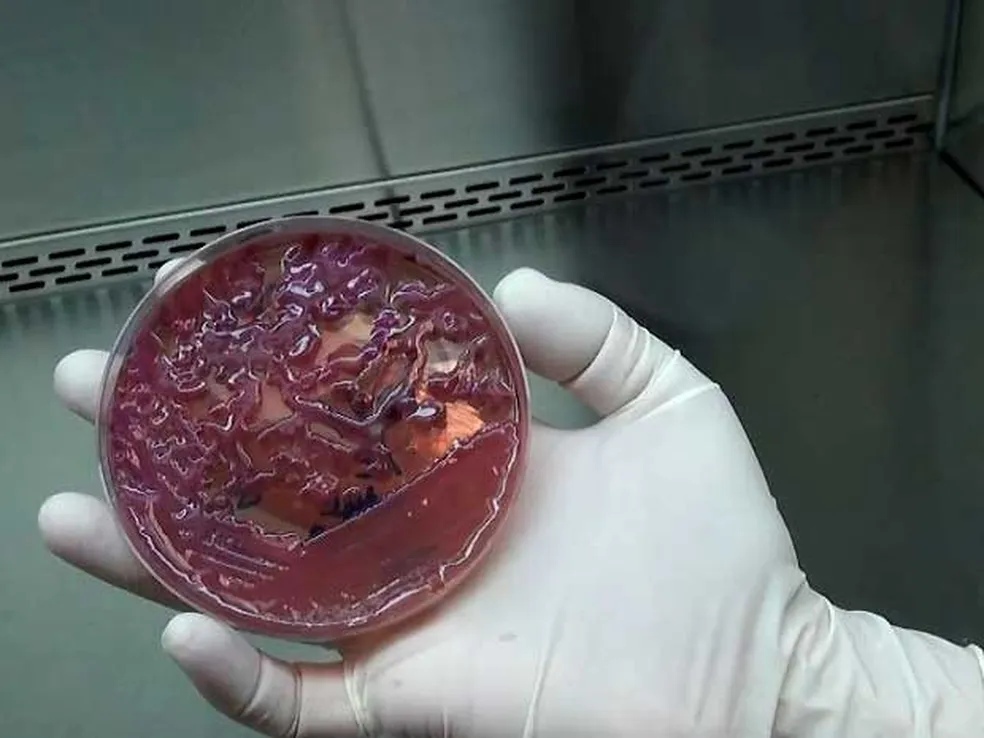
Superbactéria leva ao fechamento de UTI em hospital de Campinas

Bactéria KPC é resistente a antibióticos
Superbactéria leva ao fechamento de UTI em hospital de Campinas
A Unidade de Terapia Intensiva (UTI) do Hospital Mário Gatti, em Campinas (SP), suspendeu novas internações após a identificação da superbactéria KPC (Klebsiella Pneumoniae Carbapenemase) em sete pacientes. A administração hospitalar informou que, apesar de ser comum em ambientes hospitalares, o controle desta ocorrência tem se mostrado mais desafiador, mesmo com todos os protocolos de segurança em vigor.
A KPC é uma bactéria resistente a antibióticos que produz uma enzima capaz de destruir diversos medicamentos utilizados no tratamento de infecções bacterianas. Identificada no Brasil no início dos anos 2000, a superbactéria tem causado surtos periódicos em unidades de saúde.
* A KPC pode causar diferentes tipos de infecções, incluindo sepse, pneumonia, infecções do trato respiratório, urinárias e em feridas operatórias
* A transmissão ocorre principalmente por contato com fluidos de pessoas infectadas ou através de equipamentos médicos como ventiladores mecânicos, cateteres e sondas
* O risco é maior para pacientes internados com imunidade comprometida, especialmente em UTIs
* Os sete pacientes infectados foram isolados em um salão específico da UTI, com equipe exclusiva para atendimento
* Os outros 13 pacientes serão transferidos para enfermarias adaptadas como terapia intensiva
* Novos casos que necessitem de UTI serão encaminhados para outros hospitais da cidade
Segundo o infectologista e professor da Unicamp, Plínio Trabasso, “Elas vão se tornando resistentes aos antibióticos que a gente vai utilizando e por isso elas são mais prevalentes nesse próprio ambiente. É muito importante fazer o controle da disseminação, inclusive, porque o tratamento é dificultado”.
A coordenadora Andrea Von Zuben ressaltou que “Isso já foi feito na época da Covid e faremos novamente. Será uma exceção pacientes que irão para fora do Mário Gatti”.
O hospital mantém-se aberto para casos de urgência e emergência, e um plano de contingência foi enviado ao Departamento de Vigilância em Saúde (Devisa). Medidas preventivas já estavam em andamento, incluindo limpezas terminais de leitos, intensificação da higienização das mãos e capacitações para equipes de limpeza.